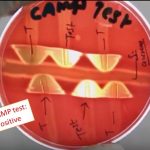

Tag: result and interpretation
Gram Stain: Introduction, Principle, Procedure, Result and Interpretation
 Introduction of Gram Stain Gram stain is a differential stain...
Introduction of Gram Stain Gram stain is a differential stain...
Indole test: Introduction,Principle, Procedure, Result and Interpretation
 Indole test for bacteria This indole test is useful for...
Indole test for bacteria This indole test is useful for...
CAMP Test: Principle, Procedure, Result and Interpretation
CAMP Test to identify presumptively S. agalactiae The CAMP test...
CAMP Test to identify presumptively S. agalactiae The CAMP test...
